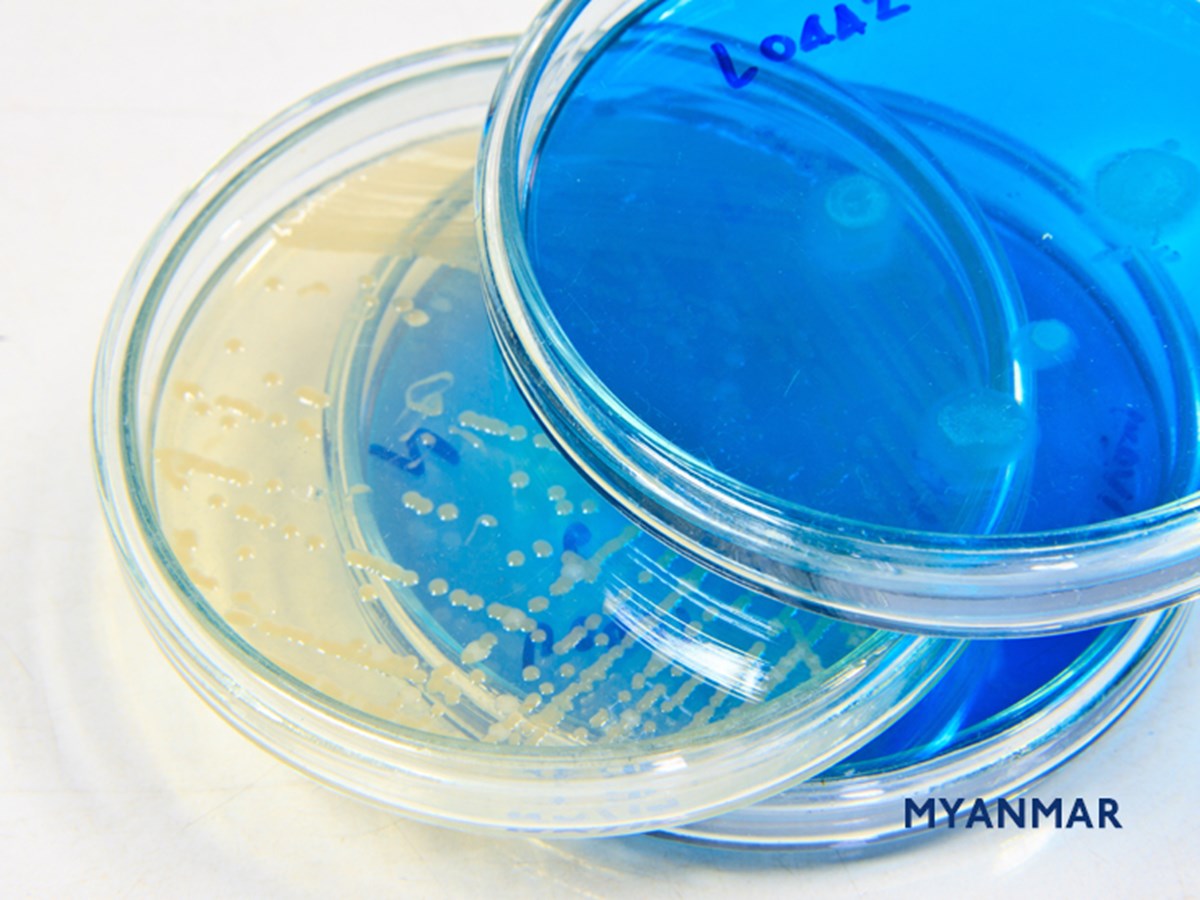

Myanmar and eight other countries affirm commitment to ensuring supply chain connectivity amid Covid-19 crisis
On 6 April 2020, Myanmar and eight other countries issued a joint ministerial statement (“Statement”) in relation to the ongoing Covid-19 crisis. This Statement adds Lao PDR and Uruguay to the countries that had previously made affirmations relating to their commitment to ensuring supply chain connectivity amid the Covid-19 pandemic.
These countries now total nine in number and are as follows: Australia, Brunei Darussalam, Canada, Chile, Lao PDR, Myanmar, New Zealand, Singapore and Uruguay (“Countries”). The Statement notes that the Countries are committed to maintaining open and connected supply chains and they will work closely to identify and address trade disruptions with ramifications on the flow of necessities.
The Statement informs that:
- the Countries recognise that it is in their mutual interest to ensure trade lines remain open, including via air and sea freight, to facilitate the flow of goods including essential supplies;
- the Countries affirm the importance of refraining from the imposition of export controls or tariffs and non-tariff barriers and of removing any existing trade restrictive measures on essential goods, especially medical supplies, at this time; and
- the Countries are committed to working with all like-minded countries to ensure that trade continues to flow unimpeded and that critical infrastructure such as air and seaports remain open to support the viability and integrity of supply chains globally.
Further information
Allen & Gledhill has a Covid-19 Resource Centre on our website www.allenandgledhill.com that contains knowhow and materials on legal and regulatory aspects of the Covid-19 crisis.
In addition, we have a cross-disciplinary Covid-19 Legal Task Force consisting of Partners across various practice areas to provide rapid assistance. Should you have any queries, please do not hesitate to get in touch with us at covid19taskforce@allenandgledhill.com.

